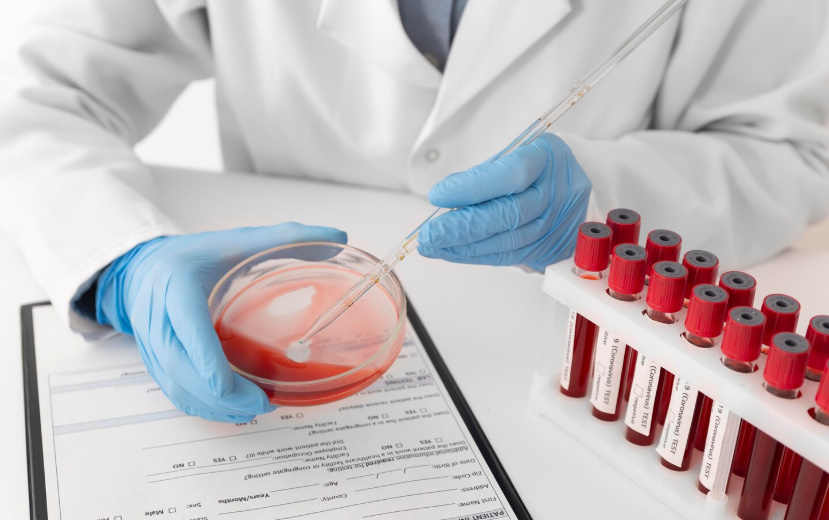

Stay informed with simple, practical advice designed to support your daily wellness. Our health tips help you build better habits, prevent illness, and make smarter choices for a healthier, longer life.
Clear, helpful explanations of GEEN specialized services—plus simple tips you can apply every day to improve your health.
What it means: Early detection saves lives. GEEN uses advanced screening tools to detect early signs of cancer—long before symptoms appear.
Wellness Tips:
Know your family history.
Schedule regular screenings (especially after age 40).
Maintain a healthy diet rich in antioxidants (berries, leafy greens).
Avoid smoking and reduce alcohol intake.

What it means: Your “biological age” shows how fast your body is aging internally—not your calendar age. GEEN gives personalized strategies to slow down this aging process.
Wellness Tips:
Get 7–8 hours of sleep per night.
Manage stress through deep breathing or short meditation.
Stay active daily (even 20–30 minutes helps).
Eat whole foods and reduce sugar.

What it means: GEEN uses precision diagnostics to find early risks and prevent diseases before you feel symptoms.
Wellness Tips:
Have annual checkups and routine labs.
Practice good hygiene, proper handwashing, and vaccination.
Keep blood pressure, cholesterol, and blood sugar monitored.

What it means: A deeper look into your health—beyond basic tests. GEEN identifies nutrient deficiencies, inflammation, hormonal imbalance, and more.
Wellness Tips:
Have your blood checked every 6–12 months.
Observe signs of fatigue, hair loss, mood changes—these may signal imbalance.
Follow supplementation as advised by your provider.
What it means: Targeted vitamin infusions and hydration therapy that boost immunity, increase energy, and support recovery.
Wellness Tips:
Drink enough water (6–8 glasses daily).
Take daily vitamins if recommended.
Rest well after receiving drips to maximize absorption.

What it means: Customized peptide treatments to enhance recovery, boost hormonal balance, and support vitality.
Wellness Tips:
Follow proper diet (high protein helps peptide functions).
Stay consistent with your treatment plan.
Inform your provider of any changes in sleep, mood, or energy.

What it means: GEEN helps you manage conditions that affect your daily life—like stress, sleep problems, and chronic fatigue.
Wellness Tips:
Create a daily routine, including time for rest.
Reduce screen time 1 hour before bedtime.
Start with small habits: daily 10-minute walk, stretching, or journaling.

What it means: Specialized treatments to slow aging from the inside out and support long-term vitality.
Wellness Tips:
Protect your skin with sunscreen.
Exercise regularly—strength training slows aging.
Prioritize sleep and hydration.

What it means: Expert care and personalized strategies to boost libido, improve energy, and enhance hormonal balance.
Wellness Tips:
Manage stress (stress reduces libido).
Exercise to improve circulation.
Communicate openly with your partner.

What it means: Personalized, science-backed programs that target weight loss from the inside out—not quick fixes.
Wellness Tips:
Eat smaller portions and choose whole foods.
Stay active daily (even short workouts count).
Avoid late-night eating and sugary drinks.

What it means: Advanced care designed to restore energy, combat fatigue, and optimize body performance.
Wellness Tips:
Stay properly hydrated.
Maintain balanced meals (protein + carbs + vegetables).
Avoid excessive caffeine—causes energy crashes.

What it means: Personalized therapies to improve mood, mental clarity, and emotional balance.
Wellness Tips:
Get sunlight for 10–15 minutes a day.
Practice mindfulness or breathing exercises.
Limit alcohol and improve sleep hygiene.

[kivicareRegisterLogin]